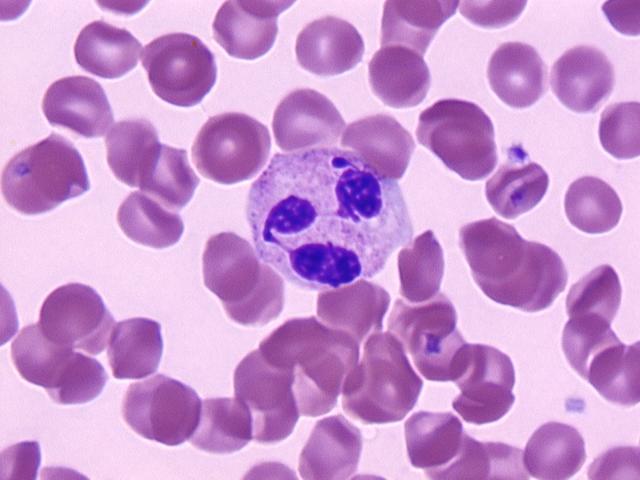

Микроскопические снимки: гистология крови в деталях

Раздел: Мудрость в объективе